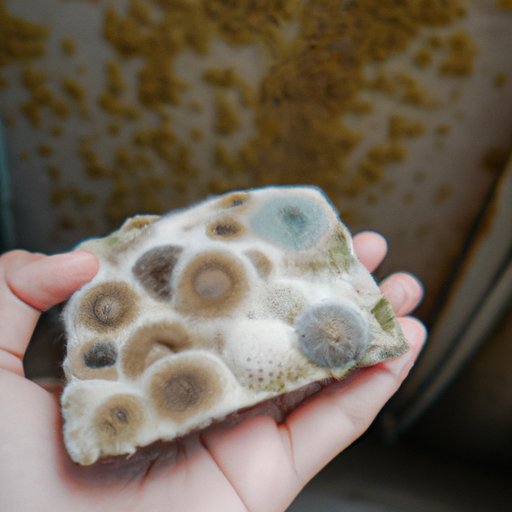
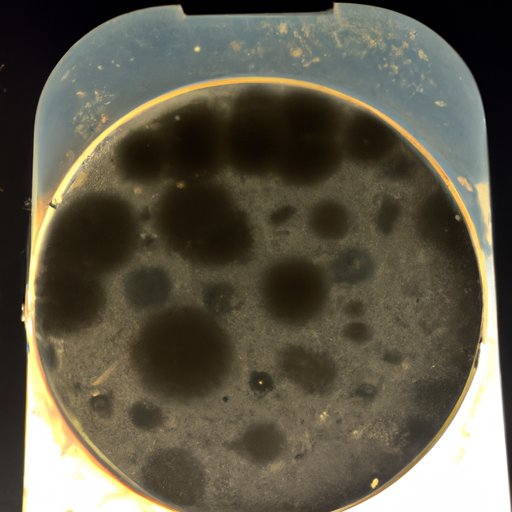

Introduction
Mold spores are microscopic particles released by fungi. They are present in the air all year round, but their concentrations can increase significantly during certain seasons or when conditions are more conducive to mold growth. Exposure to mold can cause a variety of health problems, including respiratory issues, skin and eye irritation, and allergic reactions. As such, it is important to understand how far mold spores can travel in the air and how they can be prevented from spreading.
Examining the Potential of Airborne Mold Spore Travel
The spread of mold spores through the air is largely dependent on the wind. Wind can carry mold spores great distances, sometimes even across oceans. According to a study published in the journal Environmental Pollution, “Wind-dispersed fungal propagules may travel long distances and be transported over large areas, potentially leading to the introduction of new species into areas where they did not previously exist.”
In addition to wind, other environmental factors, such as temperature, humidity, and rainfall, can also influence the spread of mold spores. For instance, high levels of humidity can create an ideal environment for mold growth and thus increase the number of mold spores in the air.

Quantifying Reach of Mold Spores in Atmosphere
Due to the complexity of the atmospheric environment, it is difficult to quantify the exact reach of mold spores in the atmosphere. However, there have been several studies that have attempted to do so. According to a study published in the journal Environmental Science & Technology, mold spores can travel up to 100 kilometers (62 miles) before settling back down in the same region. Another study published in the journal Atmospheric Environment found that the maximum distance traveled by mold spores was around 200 kilometers (124 miles).
Investigating the Distance Mold Spores Can Propagate Through Air
There are several factors that can affect the distance mold spores can travel in the air. These include wind speed, humidity, temperature, and the size of the mold spores. Wind speed is especially important as it can help or hinder the spread of mold spores depending on its direction and velocity. The higher the wind speed, the farther the mold spores will travel.
Humidity also plays an important role in mold spore dispersal. High levels of humidity can create an ideal environment for the growth of mold and thus increase the number of mold spores in the air. Temperature, on the other hand, can affect the rate at which mold spores disperse. Higher temperatures tend to reduce the amount of time it takes for mold spores to settle back down.
In addition, the size of the mold spores can also influence their reach. Smaller mold spores are more likely to remain airborne for longer periods of time than larger ones.
Strategies for Preventing the Spread of Mold Spores
There are several strategies that can be used to prevent the spread of mold spores. The most effective way to do this is to limit the growth of mold in the first place. This can be done by controlling the moisture levels in the home, fixing any leaks or water damage, and cleaning regularly. It is also important to use proper ventilation to reduce the number of mold spores in the air.
In addition, using air purifiers with HEPA filters can help to trap and remove mold spores from the air. Regularly changing filters can further reduce the risk of mold spore buildup. Finally, avoiding activities that can stir up dust and mold spores, such as vacuuming, can help to reduce the spread of mold spores.
Exploring the Limits of Airborne Mold Spore Movement
So, how far can mold spores travel through the air? While it is difficult to estimate the exact reach of mold spores, research suggests that they can travel up to 200 kilometers (124 miles) before settling back down in the same region. Of course, the exact distance will depend on a variety of environmental factors, such as wind speed, humidity, and temperature.
It is also important to consider the potential dangers of airborne mold spore movement. Inhaling mold spores can lead to a variety of health problems, including respiratory issues, skin and eye irritation, and allergic reactions. As such, it is important to take steps to prevent the spread of mold spores.
Conclusion
In conclusion, mold spores can travel great distances through the air, sometimes even across oceans. The exact distance will depend on various environmental factors, such as wind speed, humidity, and temperature. It is also important to consider the potential dangers of airborne mold spore movement and take steps to prevent their spread. By controlling moisture levels, using proper ventilation, and using air purifiers with HEPA filters, it is possible to reduce the risk of mold spore buildup.
(Note: Is this article not meeting your expectations? Do you have knowledge or insights to share? Unlock new opportunities and expand your reach by joining our authors team. Click Registration to join us and share your expertise with our readers.)